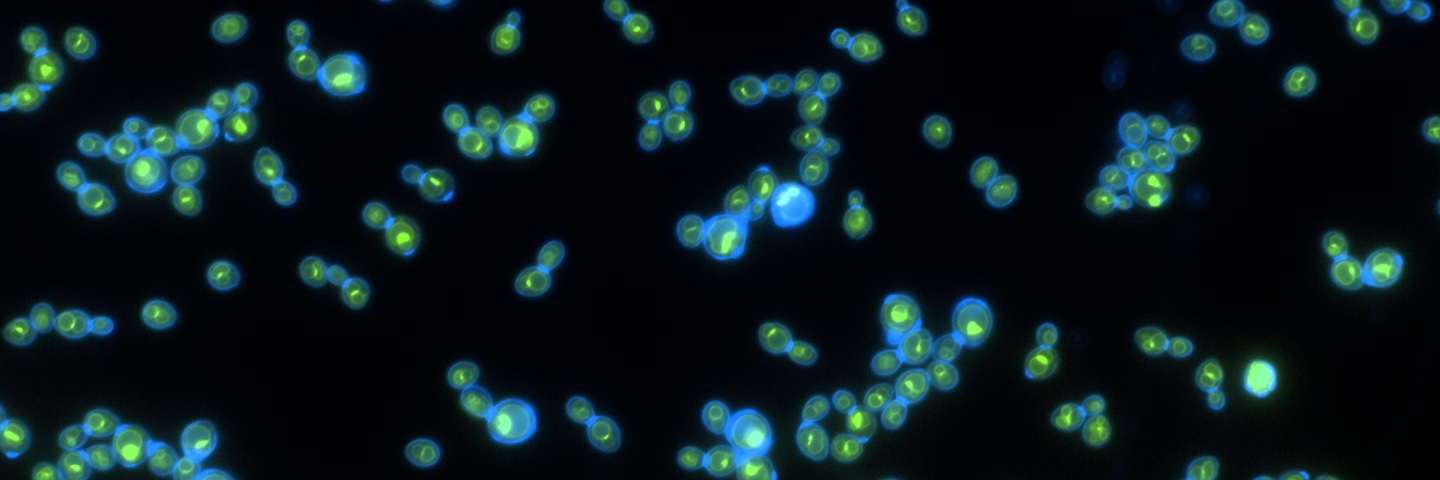
Autumn banner

Autumn
40 posts

Hey, our phototrophic yeast paper is now out in @CurrentBiology. sciencedirect.com/science/articl… This work was led by grad student @autpeterson and research scientist Tony Burnetti, and we had help from @GaTechMicrobes' Carina Baskett.




I had an amazing time at the 2023 @ABRCMS conference! I am extremely grateful for the opportunity to present a poster & assist in GT grad school recruitment as an exhibitor. I am also a new fan of Phoenix 😎🌵 #ABRCMS #CPIES











I am happy to announce that I am a 2023 HHMI Gilliam Fellow I am extremely grateful to my advisor @wc_ratcliff for his guidance and immense support throughout my academic journey. I also want to S/O my amazing support network! I’m very excited to join the @HHMINews community!
